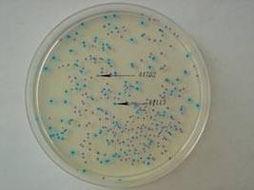
固態LB培養基

分類
液態培養基
根據《分子克隆實驗指南》(J.薩姆布魯克D.W.拉塞爾著)配製每升培養基,應該在950 ml去離子水中加入:
胰蛋白腖10g
酵母提取物5g
NaCl 10g
搖動容器直至溶質溶解.用5mol/LNaOH調pH至7.0.用去離子水定容至1L.在15psi高壓下蒸汽滅菌21min.
培養的菌種一般是經過改造的無法在外界環境單獨存活和擴增的工程菌.通過培養工程菌,我們可以表達大量的外源蛋白,也可以拿到帶有外源基因的質粒,工程菌的有效擴增是生化分子實驗的基礎.
LB培養基的配方如下:
胰蛋白腖(Tryptone) 10g/L
酵母提取物(Yeast extract) 5g/L
氯化鈉(NaCl) 10g/L
另外根據經驗值用NaOH調節該培養基的pH,使其達到7.4(該pH適合目前使用最廣的原核表達菌種E.coli的生長)
固態培養基
 固態LB培養基
固態LB培養基LB固體培養基1L和液體一樣,加10g~15g瓊脂粉,一定要在溫度降下之前加好抗
生素,並且倒好板。
固態培養基
固態LB培養基
固態LB培養基LB固體培養基1L和液體一樣,加15g瓊脂粉,一定要在溫度降下之前加好抗生素,並且倒好板。
LB固體培養基倒板
1.配製:100mlLB培養基加入1.5g瓊脂粉
2.抗生素的加入:高壓滅菌後,將融化的LB固體培養基置與55℃的水浴中,待培養基溫度降到55℃時(手可觸摸)加入抗生素,以免溫度過高導致抗生素失效,並充分搖勻。
3.倒板:一般10ml倒1個板子。培養基倒入培養皿後,打開蓋子,在紫外下照10-15分鐘。
4.保存:用封口膠封邊,並倒置放於4℃保存,一個月內使用。

